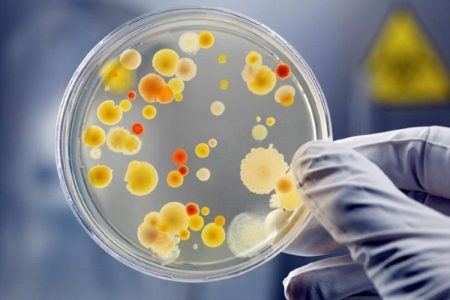

- Ангіна
- Лікування фарингіту срібла
- Лікування тонзиліту срібла
- Лікування крововиливу срібла
- Отит срібло лікування
- Лікування цукрового діабету срібла
- Лікування сріблястої онкології
- Лікування простатиту срібла
- Лікування циститу срібла
- Лікування срібної діареї
- Лікування дифтерії сріблом
- Лікування геморою срібла
Срібна вода має бактеріостатичну і бактерицидну дію, тобто руйнує або пригнічує життєздатність мікробів, бактерій, вірусів і різних видів грибів. Саме срібло як метал не має антимікробної дії на мікроорганізми. Для того, щоб срібло викликало свою антимікробну дію, його необхідно розчинити у воді до найдрібніших частинок, тобто іонів срібла. Тільки після розчинення металу іони срібла починають блокувати кисень всередині клітини, таким чином пригнічуючи його життєдіяльність. Срібляста вода вважається набагато активнішою, ніж відомі антисептики (хлор, хлорне вапно, гіпохлорит натрію та інші окислювачі). Антимікробна дія срібної води в 90 разів перевищує пеніцилін.
Хвороби Лор – органів
Для закопування в ніс при застуді по 3-4 краплі в кожну ніздрю 2 рази на день протягом 1-2 днів. При хронічному застуді рекомендується закопувати 5-6 крапель на добу
закопування в ніс при застуді по 3-4 краплі в кожну ніздрю 2 рази на день протягом 1-2 днів. При хронічному застуді рекомендується закопувати 5-6 крапель на добу
Здоров’я порожнини рота
 При інфекційних запальних процесах ротової порожнини (гінгівіт, пародонтит, стоматит) необхідно промивати рот двічі на день вранці і ввечері срібною водою. Під час полоскання можна випити 2-3 ковтки цієї води.
При інфекційних запальних процесах ротової порожнини (гінгівіт, пародонтит, стоматит) необхідно промивати рот двічі на день вранці і ввечері срібною водою. Під час полоскання можна випити 2-3 ковтки цієї води.
Респіраторні захворювання
 У разі гострого і хронічного бронхіту, що супроводжується відділенням мокротиння, пневмонії вранці п’ють натщесерце на 1/2 склянки срібної води, можна робити полоскання і інгаляції.
У разі гострого і хронічного бронхіту, що супроводжується відділенням мокротиння, пневмонії вранці п’ють натщесерце на 1/2 склянки срібної води, можна робити полоскання і інгаляції.
Захворювання шлунково-кишкового тракту
 Срібна вода допомагає позбутися від гастриту, виразки шлунка і дванадцятипалої кишки, коліту і холециститу. Необхідно приймати 1/2 склянки срібної води 2-3 рази на день за 30-40 хвилин до їжі. Дуже важливо приймати таке лікування систематично і навіть тоді, коли є поліпшення. Продовжуючи приймати лікування в профілактичних цілях, поступово зменшуйте дозу взятого срібла. А людям з низькою кислотністю, а також для посилення ефекту срібла, рекомендується додати в розчин 5-6 крапель натурального лимонного соку, попередньо настоявши воду ще 20-30 хвилин.
Срібна вода допомагає позбутися від гастриту, виразки шлунка і дванадцятипалої кишки, коліту і холециститу. Необхідно приймати 1/2 склянки срібної води 2-3 рази на день за 30-40 хвилин до їжі. Дуже важливо приймати таке лікування систематично і навіть тоді, коли є поліпшення. Продовжуючи приймати лікування в профілактичних цілях, поступово зменшуйте дозу взятого срібла. А людям з низькою кислотністю, а також для посилення ефекту срібла, рекомендується додати в розчин 5-6 крапель натурального лимонного соку, попередньо настоявши воду ще 20-30 хвилин.
Шкірні захворювання
 Срібна вода, як антисептик, застосовується у вигляді примочек, компресів або просто протирання уражених ділянок тіла при наявності грибкових захворювань шкіри і слизових оболонок. Висока ефективність і м’яка дія срібної води дозволяє використовувати іони срібла при лікуванні опіків, екземи і дерматозу. У дітей на ранніх стадіях розвитку часто з’являються висипання, почервоніння, висипання, тому дуже корисно купати їх у віці до 1 року в ваннах з додаванням сріблястої води. Діти старшого віку неминуче мають рани і синці, які також потребують лікування. З метою профілактики застуди і підвищення імунітету дітям дають випити 2-3 години. Л. срібної води 2-3 рази на день. Якщо дитина схильна до алергічних захворювань, краще обмежити прийом продуктів харчування, які викликають алергію на період лікування.
Срібна вода, як антисептик, застосовується у вигляді примочек, компресів або просто протирання уражених ділянок тіла при наявності грибкових захворювань шкіри і слизових оболонок. Висока ефективність і м’яка дія срібної води дозволяє використовувати іони срібла при лікуванні опіків, екземи і дерматозу. У дітей на ранніх стадіях розвитку часто з’являються висипання, почервоніння, висипання, тому дуже корисно купати їх у віці до 1 року в ваннах з додаванням сріблястої води. Діти старшого віку неминуче мають рани і синці, які також потребують лікування. З метою профілактики застуди і підвищення імунітету дітям дають випити 2-3 години. Л. срібної води 2-3 рази на день. Якщо дитина схильна до алергічних захворювань, краще обмежити прийом продуктів харчування, які викликають алергію на період лікування.
Цукровий діабет

Хворі на цукровий діабет часто мають важкі загоюючі рани, гнійні запалення, трофічні виразки, а на важких стадіях захворювання може призвести до синдрому діабетичної стопи. Для поліпшення стану і лікування хороший ефект можна отримати за допомогою оздоровчої ванни. Для приготування розчину в окреме емальоване блюдо наливають 1 л води, іонізують воду за допомогою іонізатора, додають 20 таблеток ацетилсаліцилової кислоти в розчин срібної води і настоюють 24 години. Отриманий розчин заливають у ванну, наповнену гарячою водою з температурою 37-40 С. Таку водну процедуру можна приймати за 10-15 хвилин до сну, щодня або через день. Достатньо 5-8 водних процедур. У важких випадках курс повторюють 4-6 разів на рік.
Купити колоїдне срібло в Києві і Україні ви можете в інтернет-магазині nanocolloids.com.ua. І пам’ятайте, що колоїдні наноколоїди срібла мають переваги перед колоїдним сріблом від NSP та інших виробників. Завдяки запатентованій плоскій формі наночастинок наше срібло краще і швидше впливає на організм, воно неіонне, нетоксичне і безпечне для вашого здоров’я. Завдяки більш високій ємності і концентрації частинок, а також доступній ціні, ми є лідерами продажів якісного срібла в Європі, підтверджених сертифікатами.

0 Likes193 Views






 закопування в ніс при застуді по 3-4 краплі в кожну ніздрю 2 рази на день протягом 1-2 днів. При хронічному застуді рекомендується закопувати 5-6 крапель на добу
закопування в ніс при застуді по 3-4 краплі в кожну ніздрю 2 рази на день протягом 1-2 днів. При хронічному застуді рекомендується закопувати 5-6 крапель на добу При інфекційних запальних процесах ротової порожнини (гінгівіт, пародонтит, стоматит) необхідно промивати рот двічі на день вранці і ввечері срібною водою. Під час полоскання можна випити 2-3 ковтки цієї води.
При інфекційних запальних процесах ротової порожнини (гінгівіт, пародонтит, стоматит) необхідно промивати рот двічі на день вранці і ввечері срібною водою. Під час полоскання можна випити 2-3 ковтки цієї води. У разі гострого і хронічного бронхіту, що супроводжується відділенням мокротиння, пневмонії вранці п’ють натщесерце на 1/2 склянки срібної води, можна робити полоскання і інгаляції.
У разі гострого і хронічного бронхіту, що супроводжується відділенням мокротиння, пневмонії вранці п’ють натщесерце на 1/2 склянки срібної води, можна робити полоскання і інгаляції. Срібна вода допомагає позбутися від гастриту, виразки шлунка і дванадцятипалої кишки, коліту і холециститу. Необхідно приймати 1/2 склянки срібної води 2-3 рази на день за 30-40 хвилин до їжі. Дуже важливо приймати таке лікування систематично і навіть тоді, коли є поліпшення. Продовжуючи приймати лікування в профілактичних цілях, поступово зменшуйте дозу взятого срібла. А людям з низькою кислотністю, а також для посилення ефекту срібла, рекомендується додати в розчин 5-6 крапель натурального лимонного соку, попередньо настоявши воду ще 20-30 хвилин.
Срібна вода допомагає позбутися від гастриту, виразки шлунка і дванадцятипалої кишки, коліту і холециститу. Необхідно приймати 1/2 склянки срібної води 2-3 рази на день за 30-40 хвилин до їжі. Дуже важливо приймати таке лікування систематично і навіть тоді, коли є поліпшення. Продовжуючи приймати лікування в профілактичних цілях, поступово зменшуйте дозу взятого срібла. А людям з низькою кислотністю, а також для посилення ефекту срібла, рекомендується додати в розчин 5-6 крапель натурального лимонного соку, попередньо настоявши воду ще 20-30 хвилин. Срібна вода, як антисептик, застосовується у вигляді примочек, компресів або просто протирання уражених ділянок тіла при наявності грибкових захворювань шкіри і слизових оболонок. Висока ефективність і м’яка дія срібної води дозволяє використовувати іони срібла при лікуванні опіків, екземи і дерматозу. У дітей на ранніх стадіях розвитку часто з’являються висипання, почервоніння, висипання, тому дуже корисно купати їх у віці до 1 року в ваннах з додаванням сріблястої води. Діти старшого віку неминуче мають рани і синці, які також потребують лікування. З метою профілактики застуди і підвищення імунітету дітям дають випити 2-3 години. Л. срібної води 2-3 рази на день. Якщо дитина схильна до алергічних захворювань, краще обмежити прийом продуктів харчування, які викликають алергію на період лікування.
Срібна вода, як антисептик, застосовується у вигляді примочек, компресів або просто протирання уражених ділянок тіла при наявності грибкових захворювань шкіри і слизових оболонок. Висока ефективність і м’яка дія срібної води дозволяє використовувати іони срібла при лікуванні опіків, екземи і дерматозу. У дітей на ранніх стадіях розвитку часто з’являються висипання, почервоніння, висипання, тому дуже корисно купати їх у віці до 1 року в ваннах з додаванням сріблястої води. Діти старшого віку неминуче мають рани і синці, які також потребують лікування. З метою профілактики застуди і підвищення імунітету дітям дають випити 2-3 години. Л. срібної води 2-3 рази на день. Якщо дитина схильна до алергічних захворювань, краще обмежити прийом продуктів харчування, які викликають алергію на період лікування.